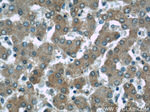
NDUFS5 Antibody in Immunohistochemistry (Paraffin) (IHC (P))

Search
Proteintech
NDUFS5 Monoclonal Antibody (2C2A5)
{{$productOrderCtrl.translations['antibody.pdp.commerceCard.promotion.promotions']}}
{{$productOrderCtrl.translations['antibody.pdp.commerceCard.promotion.viewpromo']}}
{{$productOrderCtrl.translations['antibody.pdp.commerceCard.promotion.promocode']}}: {{promo.promoCode}} {{promo.promoTitle}} {{promo.promoDescription}}. {{$productOrderCtrl.translations['antibody.pdp.commerceCard.promotion.learnmore']}}
产品信息
66053-1-IG
种属反应
宿主/亚型
分类
类型
克隆号
抗原
偶联物
形式
浓度
纯化类型
保存液
内含物
保存条件
运输条件
产品详细信息
Proteintech's NDUFS5 antibody 66053-1-Ig is capable of detecting the 15 kDa protein in Western blotting.
Immunogen sequence: MPFLDIQKR FGLNIDRWLT IQSGEQPYKM AGRCHAFEKE WIECAHGIGY TRAEKECKIE YDDFVECLLR QKTMRRAGTI RKQRDKLIKE GKYTPPPHHI GKGEPRP (1-106 aa encoded by BC001884)
靶标信息
Located in the mitochondrial inner membrane, mitochondrial complex I is the first and largest enzyme in the electron transport chain of oxidative phosphorylation. By oxidizing NADH that is produced in the Krebs cycle, this complex utilizes the two electrons to reduce ubiquinone to ubiquinol, thereby initiating the passage of electrons to successive complexes and ultimately leading to the reduction of oxygen to water. Mitochondrial complex I consists of over 40 subunits and is of considerable clinical interest since defects in any of the subunits can lead to various myopathies and neuropathies. As a subunit of mitochondrial complex I, NDUFS5 (NADH dehydrogenase [ubiquinone] iron-sulfur protein 5), also designated NADH-ubiquinone oxidoreductase 15 kDa subunit, is a 106 amino acid protein that is suggested to not be involved in catalysis. NDUFS5 is expressed ubiquitously in human tissues, with a relative higher expression in human heart, skeletal muscle, liver, kidney and fetal heart.
仅用于科研。不用于诊断过程。未经明确授权不得转售。
篇参考文献 (0)
生物信息学
蛋白别名: CI-15 kDa; Complex I-15 kDa; NADH dehydrogenase (ubiquinone) Fe-S protein 5, 15kDa (NADH-coenzyme Q reductase); NADH dehydrogenase [ubiquinone] iron-sulfur protein 5; NADH-ubiquinone oxidoreductase 15 kDa subunit; NADH:ubiquinone oxidoreductase 15 kDa IP subunit
基因别名: CI-15k; CI15K; NDUFS5
UniProt ID: (Human) O43920
Entrez Gene ID: (Human) 4725